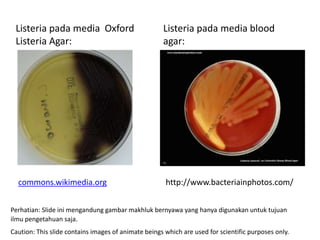
Listeria pada media blood
agar:
http://www.bacteriainphotos.com/
commons.wikimedia.org
Listeria pada media Oxford
Listeria Agar:
Perhatian: Slide ini mengandung gambar makhluk bernyawa yang hanya digunakan untuk tujuan
ilmu pengetahuan saja.
Caution: This slide contains images of animate beings which are used for scientific purposes only.

Listeria adalah bakteri Gram positif yang dapat diisolasi dari tanah dan silase. Bakteri ini dapat menyebabkan infeksi seperti septicemia, meningitis, dan infeksi janin pada wanita hamil yang dapat menyebabkan keguguran. Populasi rentan terhadap listeriosis antara lain wanita hamil, sistem kekebalan tubuh lemah, kanker, dan lansia. Diagnosis pasti membutuhkan isolasi bakteri dari darah atau cairan serebrosp